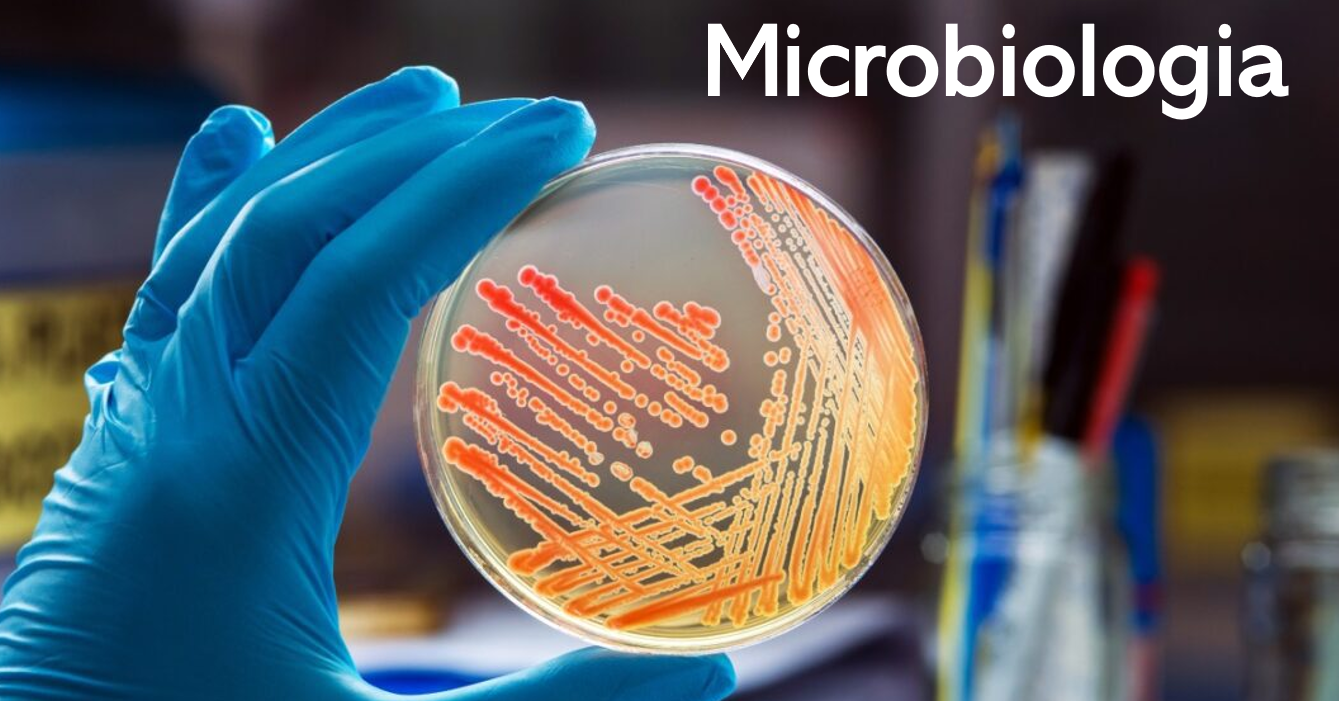

Codice insegnamento 65537
Ricevimento Luigi Vezzulli: Il ricevimento degli studenti sara concordato direttamente con il docente.
Inizio lezioni: Consultare orario dettagliato al seguente link: https://easyacademy.unige.it/portalestudenti/
Si rimanda all'istanza AulaWeb specifica dell'insegnamento per eventuali aggiornamenti a causa di variazioni della situazione sanitaria ed epidemiologica.
Corsi di laurea, sedi, programma, obiettivi, modalità d'esame e altre informazioni
- Docente: Luigi Vezzulli